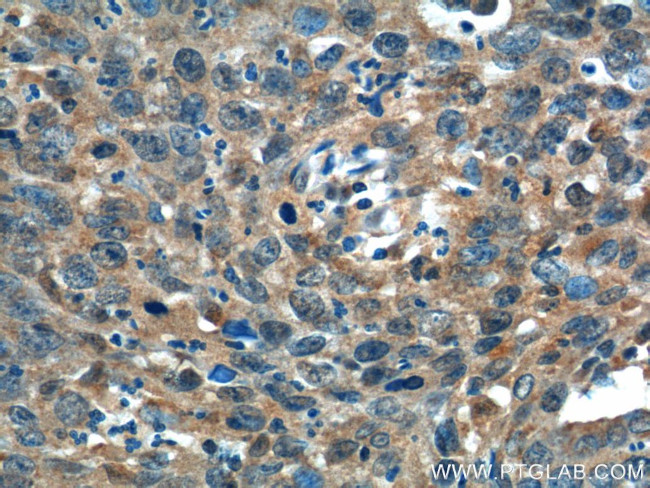
ADA Antibody in Immunohistochemistry (Paraffin) (IHC (P))
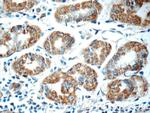
ADA Antibody in Immunohistochemistry (Paraffin) (IHC (P))

Search
Proteintech
ADA Polyclonal Antibody
{{$productOrderCtrl.translations['antibody.pdp.commerceCard.promotion.promotions']}}
{{$productOrderCtrl.translations['antibody.pdp.commerceCard.promotion.viewpromo']}}
{{$productOrderCtrl.translations['antibody.pdp.commerceCard.promotion.promocode']}}: {{promo.promoCode}} {{promo.promoTitle}} {{promo.promoDescription}}. {{$productOrderCtrl.translations['antibody.pdp.commerceCard.promotion.learnmore']}}
产品信息
13328-1-AP
种属反应
宿主/亚型
分类
类型
抗原
偶联物
形式
浓度
规格
纯化类型
保存液
内含物
保存条件
运输条件
产品详细信息
Immunogen sequence: MAQTPAFDK PKVELHVHLD GSIKPETILY YGRRRGIALP ANTAEGLLNV IGMDKPLTLP DFLAKFDYYM PAIAGCREAI KRIAYEFVEM KAKEGVVYVE VRYSPHLLAN SKVEPIPWNQ AEGDLTPDEV VALVGQGLQE GERDFGVKAR SILCCMRHQP NWSPKVVELC KKYQQQTVVA IDLAGDETIP GSSLLPGHVQ AYQEAVKSGI HRTVHAGEVG SAEVVKEAVD ILKTERLGHG YHTLEDQALY NRLRQENMHF EICPWSSYLT GAWKPDTEHA VIRLKNDQAN YSLNTDDPLI FKSTLDTDYQ MTKRDMGFTE EEFKRLNINA AKSSFLPEDE KRELLDLLYK AYGMPPSASA GQNL (1-363 aa encoded by BC040226)
靶标信息
Catalyzes the hydrolytic deamination of adenosine and 2-deoxyadenosine. Plays an important role in purine metabolism and in adenosine homeostasis. Modulates signaling by extracellular adenosine, and so contributes indirectly to cellular signaling events. May act as a positive regulator of T-cell coactivation.
仅用于科研。不用于诊断过程。未经明确授权不得转售。
生物信息学
蛋白别名: Adenosine aminohydrolase; Adenosine deaminase; RP11-61L14.5
基因别名: ADA; ADA1
UniProt ID: (Human) P00813, (Mouse) P03958
Entrez Gene ID: (Human) 100, (Mouse) 11486